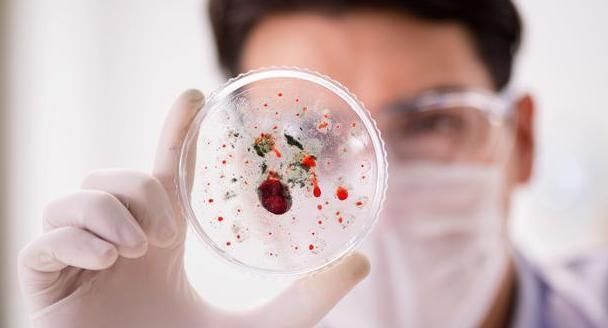
癌基因|肿瘤的发展,分为5个阶段,到了晚期基本就“无力回天”!

癌基因|肿瘤的发展,分为5个阶段,到了晚期基本就“无力回天”!
肿瘤,是指机体在各种致瘤因子作用下,局部组织细胞增生所形成的新生物。简单来说,肿瘤就是由正常细胞失控生长变成的癌细胞过度分类而形成的肿块。总之,肿瘤的病因其实就是因为不明情况下导致正常细胞异变成癌细胞。换言之,肿瘤的发生是内外致病因素的共同作用下逐步发展的过程,比如环境因素、遗传因素、饮食习惯等等。
文章插图
一般来说,肿瘤的发展分为五个阶段:
第一、是还不算癌细胞的癌前阶段。在每个细胞内都有一种原癌基因和抑癌基因,而正常细胞之所以能够异变成癌细胞,最关键的就是原癌细胞被激活以及抑癌基因被抑制。在两者的相互作用下,正常细胞也就异变成癌细胞。
第二、是细胞刚刚恶变,变成癌细胞,进入原位癌阶段。当一个正常细胞异变成癌细胞的时候,这个细胞将不受人体正常的生理系统控制,而是放飞自我,自主分裂出多个癌细胞。然后,在多个癌细胞堆积起来之后就形成了肿块,也就是成长为肿瘤。

文章插图
【 癌基因|肿瘤的发展,分为5个阶段,到了晚期基本就“无力回天”!】第三、是癌细胞会向深处开始浸润,成为浸润癌阶段。癌细胞不仅仅是无限制地增殖,还会与正常体细胞竞争人体内的营养。虽然最初是正常细胞,但是成了癌细胞之后就和正常体细胞就敌对的关系。又由于最初是正常细胞,所以能避开人体免疫系统的识别,最终无法靠人体自身的免疫功能消灭也就是没有天敌的存在,也就能够无后顾之忧地分裂增殖。
第四、是癌细胞突然开始进行移动,进入到转移阶段。一旦发生转移,就很难治疗了。很多患者发现肿瘤往往是在转移的时候,因为这个时候症状才比较明显。

文章插图
第五、是向远处播散阶段。位于远处的器官开始受到影响,这时候往往是晚期了。
除此之外,肿瘤还会根据癌细胞的性质分有良性和恶性。其中,具有局部侵犯和转移能力的肿瘤就是恶性肿瘤,而只是无限增殖分裂的就是良性肿瘤,恶性肿瘤的危害性比良性肿瘤的危害性更大。
肿瘤经历了癌前病变、原位癌,如果是恶性肿瘤在后期还有浸润癌,局部或区域淋巴结转移,远处转移等阶段阶段。但是,良性肿瘤也有可能因为其他因素的影响发生癌变的。所以,无论是良性还是恶性,它的发展都是有一定过程的,越早发现,治疗难度就越小。
本文指导专家:
- 免疫|1碗抗癌汤消炎、抗氧化、强免疫!利用大白菜、菇类快速搞定
- 潜伏在我们身边的这3种“致癌”蔬菜,看完你还敢继续吃吗?
- 饮食习惯|咸鱼腊肉很好吃,但吃多了真的会致癌?牢记3点,或无后顾之忧
- 羊肉|羊肉到底是“致癌杀手”还是“营养佳品”呢?世卫组织揭晓答案
- 脏腑|重庆肿瘤专科医院:中医帮你调和气血,平衡阴阳
- 相关|【中国实用外科杂志】肥胖代谢病合并甲状腺癌外科治疗中国专家共识(2021版)
- 成都|健康科普|被列为明确致癌物!一半胃癌与它有关…
- 预防肿瘤|夜里温度下降孩子睡不好,多吃营养菜,补虚暖胃,提高抵抗力
- 浴室里的“它”,可能是癌症帮凶,多数人洗澡时比较喜欢用
- 体内有癌,腰背先知晓?出现这2种标志,或是癌症“警告”?
